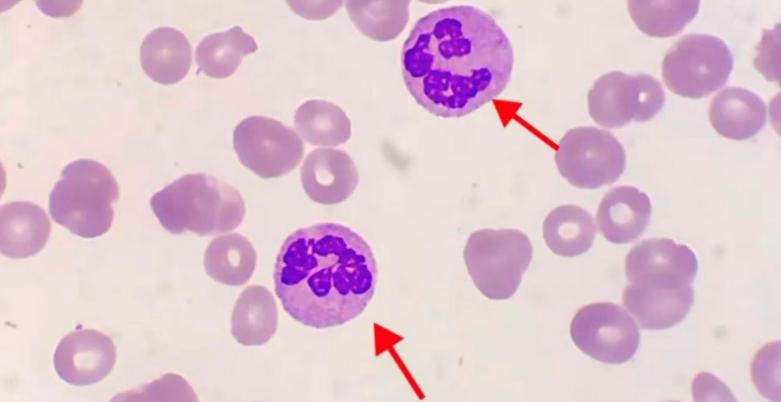

【健康第一课16】 中性粒细胞核象变化与临床意义 |
[ 信息发布:本站 | 发布时间:2025-09-24 | 浏览:17761次 ] |
核象变化是指中性粒细胞细胞核形态的异常改变,主要包括核左移和核右移。 正常情况下外周血中性粒细胞主要以分叶核为主,胞核以3叶核为主杆状核较少,分叶核与杆状核比值为13 :1。在病理情况下会打破此比例,即核左移或核右移。 一、核左移 外周血杆状核增多并出现晚幼粒甚至早幼粒细胞,常伴有明显的胞体大小不等、中毒颗粒、核变性等质的改变。急性感染是最常见的原因,特别是化脓性细菌感染。 (一)依据杆状核粒细胞百分比可分为轻度、中度及重度。 1.轻度核左移(杆状核粒细胞 > 6%):常提示轻度感染。 2.中度核左移(杆状核粒细胞 > 10%,可伴有少量晚幼粒细胞):提示中度至重度感染。 3.重度核左移(杆状核粒细胞 > 25%,出现更幼稚的细胞,如早、中幼粒细胞):考虑“类白血病反应”。 4.急性中毒:如尿毒症、糖尿病酮症酸中毒、急性铅、汞中毒等。 5.急性溶血或失血:机体应激反应导致骨髓加速释放粒细胞。 6.急性髓系白血病(AML),外周血中会出现大量原始、幼稚细胞,这是一种极度的、病理性的“核左移”。 (二)依据白细胞总数区分 1.再生性核左移:白细胞总数增高,同时伴有核左移。表示骨髓造血功能良好,机体抵抗力强。常见于大多数急性感染。 2.退行性核左移:白细胞总数正常或减低,但核左移明显。表示骨髓造血功能衰竭或受损,释放功能发生障碍,是预后不良的征兆。常见于严重感染、机体抵抗力低下时。 (三)其他核象异常 中毒性变化:在严重感染、中毒或肿瘤时,中性粒细胞胞浆和胞核可出现以下异常改变: 1.中毒颗粒:胞浆中出现粗大的深紫色颗粒。
(图1含中毒颗粒的中性粒细胞) 2.空泡形成:胞浆或核内出现空泡,常提示细胞发生吞噬或退化。
(图2 中性粒细胞空泡变性) 3.杜勒小体:胞浆中蓝色的斑块状区域。
(图3 杜勒小体) 4.其他:核固缩、核溶解等退行性变现象。 这些变化与核左移同时出现,进一步支持存在严重感染或中毒状态。 二、核右移 外周血中五叶核及五叶核以上的中性粒细胞>3%,常伴随白细胞总数减少,属造血衰退表现。
(图4多分叶核中性粒细胞) 主要见于:巨幼细胞性贫血、骨髓增生异常综合征、化疗后。 特别指出在炎症恢复期可出现一过性核右移现象。但是在疾病进展期突然出现此现象可提示预后不良。 总结一下,中性粒细胞的核象变化是血常规检查中一个低成本、高价值的动态监测指标。实验室通过借助血涂片仔细观察并准确报告核象变化,能为临床医生提供超越单纯白细胞计数的深层信息,对于早期识别严重感染、鉴别诊断感染类型和贫血原因、评估病情严重程度和机体反应能力、判断预后和疗效观察,具有不可替代的重要作用。
撰稿:周 琦 审核:周稚喆 校对:张皓雯 责编:李 泽
|
| 打印 | 关闭 |